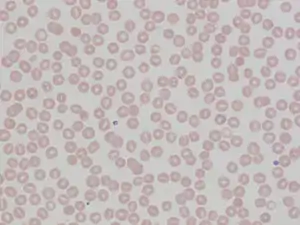

Hereditary stomatocytosis
Hereditary stomatocytosis describes a number of inherited, mostly autosomal dominant human conditions which affect the red blood cell and create the appearance of a slit-like area of central pallor (stomatocyte) among erythrocytes on peripheral blood smear. The erythrocytes' cell membranes may abnormally 'leak' sodium and/or potassium ions, causing abnormalities in cell volume.[1] Hereditary stomatocytosis should be distinguished from acquired causes of stomatocytosis, including dilantin toxicity and alcoholism, as well as artifact from the process of preparing peripheral blood smears.[2]: 237
| Hereditary stomatocytosis | |
|---|---|
![]() | |
| Stomatocytes | |
| Specialty | Hematology |

Signs and symptoms
Stomatocytosis may present with signs and symptoms consistent with hemolytic anemia as a result of extravascular hemolysis and often intravascular hemolysis. These include fatigue and pallor, as well as signs of jaundice, splenomegaly and gallstone formation from prolonged hemolysis.[1][3] Certain cases of hereditary stomatocytosis associated with genetic syndromes have additional symptoms that are unrelated to the hemolytic anemia.[1]
Pathophysiology
The two varieties of stomatocytosis classified with respect to cellular hydration status are overhydrated (hydrocytosis) and dehydrated (xerocytosis).[2]: 225–226 Hereditary xerocytosis is characterized by autosomal dominant mutations in PIEZO1, which encodes a cation channel whose mechanosensitive properties enable erythrocytes to deform as they pass through narrow capillaries by decreasing their intracellular volume.[4] More rarely, hereditary xerocytosis may be caused by mutations in KCNN4, which encodes a calcium ion-sensitive potassium channel that mediates the potassium efflux triggered by a rise in intracellular Ca2+ via activated PIEZO1 channels.[4] Hereditary xerocytosis occurs more commonly in African populations,[2][4] and it exhibits complex interactions with other hereditary alterations of red blood cells, including sickle cell disease[4][5] and malaria resistance.[4][6]
Osmosis leads to the red blood cell having a constant tendency to swell and burst. This tendency is countered by manipulating the flow of sodium and potassium ions. A 'pump' forces sodium out of the cell and potassium in, and this action is balanced by a process called 'the passive leak'. In overhydrated hereditary stomatocytoses, the passive leak is increased and the erythrocyte becomes swamped with salt and water. The affected erythrocytes have increased osmotic fragility.[4] Haemolytic anaemia results. For as yet unknown reasons, the cells take on the shape of a cup, with a 'mouth-shaped' (stoma) area of central pallor.
Overhydrated hereditary stomatocytosis is frequently linked to mutations in genes that encode components of the band 3 complex, such as RHAG.[4] It is the altered band 3 protein complex which mediates the cation leaks that are characteristic of hydrocytotic hereditary stomatocytosis.[7]
Rare cases of hereditary spherocytosis can occur without cation leaks. These include cases of phytosterolemia nonleaky stomatocytosis, a disorder of lipid metabolism associated with mutations in ABCG5 and/or ABCG8, which encode sterol transporters.[1] The resulting abnormal sterol composition of erythrocyte cell membranes causes them to appear as deformed stomatocytes on peripheral blood smear.[1]
Diagnosis
Ektacytometry may be helpful in distinguishing different subtypes of hereditary stomatocytosis.[4]
Variants
Haematologists have identified a number of variants. These can be classified as below.
- Overhydrated hereditary stomatocytosis[1]
- Dehydrated hereditary stomatocytosis (hereditary xerocytosis; hereditary hyperphosphatidylcholine haemolytic anaemia)[8]
- Dehydrated hereditary stomatocytosis with perinatal edema and/or pseudohyperkalemia[1]
- Cryohydrocytosis[1]
- 'Blackburn' variant[8]
- Familial pseudohyperkalaemia (not associated with hemolytic anemia)[1]
There are other families that do not fall neatly into any of these classifications.[9]
Stomatocytosis is also found as a hereditary disease in Alaskan malamute and miniature schnauzer dogs.[10]
Treatment
At present there is no specific treatment. Many patients with hemolytic anemia take folic acid (vitamin B9) since the greater turnover of cells consumes this vitamin. During crises transfusion may be required. Clotting problems can occur for which anticoagulation may be needed. Unlike hereditary spherocytosis, splenectomy is contraindicated.[11]
References
- Andolfo I, Russo R, Gambale A, Iolascon A (January 2018). "Hereditary stomatocytosis: An underdiagnosed condition". American Journal of Hematology. 93 (1): 107–121. doi:10.1002/ajh.24929. PMID 28971506.
- Tyrrell, L; Rose, G; Shukri, A; Kawash, SB (2021). "Morphologic changes in red blood cells: An illustrated review of clinically important light microscopic findings" (PDF). The Malaysian Journal of Pathology. 43 (2): 219–239. PMID 34448787. Retrieved 12 September 2022.
- Phillips J, Henderson AC (September 2018). "Hemolytic Anemia: Evaluation and Differential Diagnosis". American Family Physician. 98 (6): 354–361. PMID 30215915. Retrieved 5 September 2022.
- Risinger, Mary; Kalfa, Theodosia A. (2020). "Red cell membrane disorders: Structure meets function". Blood. 136 (11): 1250–1261. doi:10.1182/blood.2019000946. PMC 7483429. PMID 32702754.
- Ilboudo, Yann; Bartolucci, Pablo; Garrett, Melanie E.; Ashley-Koch, Allison; Telen, Marilyn; Brugnara, Carlo; Galactéros, Frédéric; Lettre, Guillaume (2018). "A common functional PIEZO1 deletion allele associates with red blood cell density in sickle cell disease patients". American Journal of Hematology. 93 (11): E362–E365. doi:10.1002/ajh.25245. PMID 30105803.
- Nguetse, Christian N.; Purington, Natasha; Ebel, Emily R.; Shakya, Bikash; Tetard, Marilou; Kremsner, Peter G.; Velavan, Thirumalaisamy P.; Egan, Elizabeth S. (2020). "A common polymorphism in the mechanosensitive ion channel PIEZO1 is associated with protection from severe malaria in humans". Proceedings of the National Academy of Sciences. 117 (16): 9074–9081. Bibcode:2020PNAS..117.9074N. doi:10.1073/pnas.1919843117. PMC 7183233. PMID 32265284.
- Bruce LJ, Robinson HC, Guizouarn H, Borgese F, Harrison P, King MJ, et al. (November 2005). "Monovalent cation leaks in human red cells caused by single amino-acid substitutions in the transport domain of the band 3 chloride-bicarbonate exchanger, AE1". Nature Genetics. 37 (11): 1258–1263. doi:10.1038/ng1656. PMID 16227998. S2CID 23554234.
- Coles SE, Stewart GW (October 1999). "Temperature effects on cation transport in hereditary stomatocytosis and allied disorders". International Journal of Experimental Pathology. 80 (5): 251–258. doi:10.1046/j.1365-2613.1999.00120.x. PMC 2517829. PMID 10607015.
- Oski FA, Naiman JL, Blum SF, Zarkowsky HS, Whaun J, Shohet SB, et al. (April 1969). "Congenital hemolytic anemia with high-sodium, low-potassium red cells. Studies of three generations of a family with a new variant". The New England Journal of Medicine. 280 (17): 909–916. doi:10.1056/NEJM196904242801701. PMID 4237839.
- Thrall MA, Baker DC (2006). Veterinary Hematology and Clinical Chemistry. Blackwell Publishing. pp. 71–72. ISBN 978-0-7817-5799-7. OCLC 954019258.
- Picard V, Guitton C, Thuret I, Rose C, Bendelac L, Ghazal K, et al. (August 2019). "Clinical and biological features in PIEZO1-hereditary xerocytosis and Gardos channelopathy: a retrospective series of 126 patients". Haematologica. 104 (8): 1554–1564. doi:10.3324/haematol.2018.205328. PMC 6669138. PMID 30655378.
Further reading
- Eber SW, Lande WM, Iarocci TA, Mentzer WC, Höhn P, Wiley JS, Schröter W (July 1989). "Hereditary stomatocytosis: consistent association with an integral membrane protein deficiency". British Journal of Haematology. 72 (3): 452–455. doi:10.1111/j.1365-2141.1989.tb07731.x. PMID 2765409. S2CID 44935457.
- Hiebl-Dirschmied CM, Adolf GR, Prohaska R (June 1991). "Isolation and partial characterization of the human erythrocyte band 7 integral membrane protein". Biochimica et Biophysica Acta (BBA) - Biomembranes. 1065 (2): 195–202. doi:10.1016/0005-2736(91)90230-6. PMID 1711899.
- Hiebl-Dirschmied CM, Entler B, Glotzmann C, Maurer-Fogy I, Stratowa C, Prohaska R (August 1991). "Cloning and nucleotide sequence of cDNA encoding human erythrocyte band 7 integral membrane protein". Biochimica et Biophysica Acta (BBA) - Gene Structure and Expression. 1090 (1): 123–124. doi:10.1016/0167-4781(91)90047-P. PMID 1883838.
- Stewart GW, Hepworth-Jones BE, Keen JN, Dash BC, Argent AC, Casimir CM (March 1992). "Isolation of cDNA coding for an ubiquitous membrane protein deficient in high Na+, low K+ stomatocytic erythrocytes". Blood. 79 (6): 1593–1601. doi:10.1182/blood.V79.6.1593.1593. PMID 1547348.